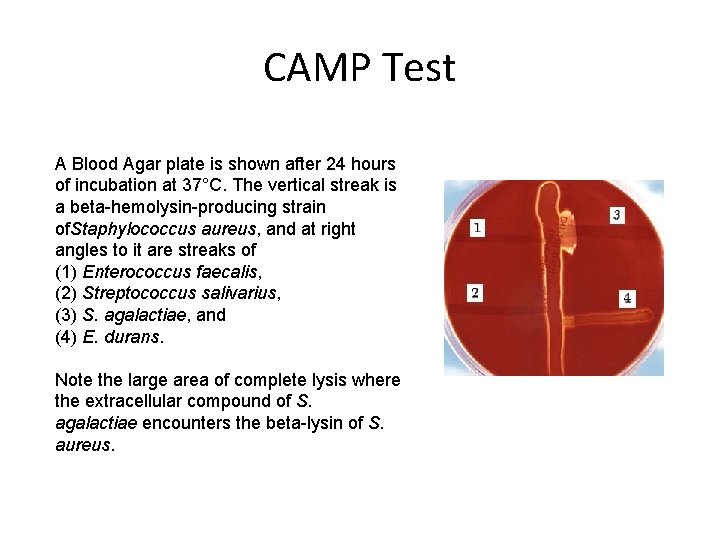
CAMP Test A Blood Agar plate is shown after 24 hours of incubation at
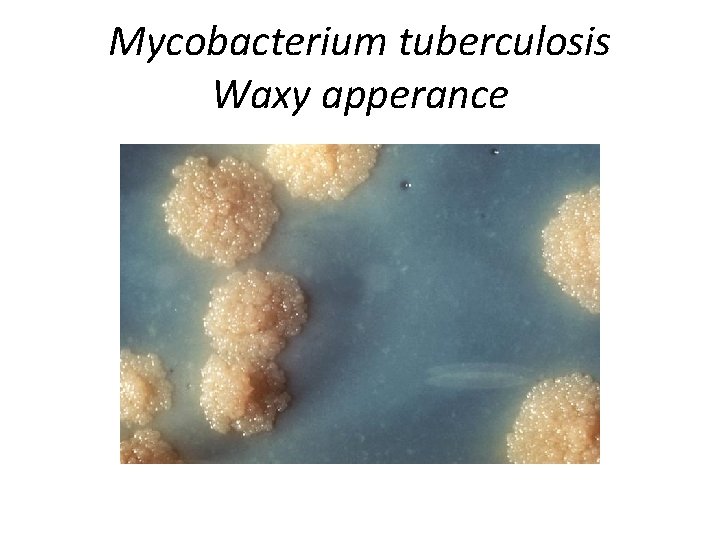
Mycobacterium tuberculosis Waxy apperance

Rebecca Lancefield Classification She is most famous for

Rebecca Lancefield Classification She is most famous for her serological classification of betahemolytic streptococcal bacteria, which is based on the carbohydrate composition of bacterial antigens found on their cell walls. The Lancefield classification system is still used internationally today. Group A - Streptococcus pyogenes Group B - Streptococcus agalactiae Group C - Streptococcus equisimilis, Streptococcus equi, S. dysgalactiae Group D - Enterococci, Streptococcus bovis Group E - Streptococcus mutans Gp C and D – not important for humans

Streptococcus pyogenes

Fig. a) Gram stain of sputum S. pneumonia; b) Alpha hemolysis on BA

Streptococcal tests: a) A rapid direct test kit for diagnosis of Gr A infections Patient throat sample is mixed with latex beads and Mc. Ab Left- Carb on Gr A strep forms clumps but on R- a smooth milky Rx- (-) b) S. pyogenes is is sensitive (+) to Bacitracin disc but (-) to Sulph-TMP and CAMP test (-)

CAMP Test CAMP is an acronym for Christie, Atkins, Munch- Petersen, the discoverers of this phenomenon. This procedure is used to confirm that a bacterial strain is a Group B streptococcus by production of a characteristic zone of hemolysis when grown in proximity to S. aureus. Streptococcus agalactiae (also known as Group B streptococcus or GBS) is a beta-hemolytic Gram + streptcoccus
CAMP Test A Blood Agar plate is shown after 24 hours of incubation at 37°C. The vertical streak is a beta-hemolysin-producing strain of. Staphylococcus aureus, and at right angles to it are streaks of (1) Enterococcus faecalis, (2) Streptococcus salivarius, (3) S. agalactiae, and (4) E. durans. Note the large area of complete lysis where the extracellular compound of S. agalactiae encounters the beta-lysin of S. aureus.

Fig. 21 - The course of bacterial Pneumonia

Mycoplasma Colonies "fried-egg" because they form a dense central core, which penetrates downward into the agar, surrounded by a circular spreading area that is lighter in color.

Fig. 21. 22

Histoplasma capsulatum Sign in wooded area with birds dropping; up to 90% of Ohio valley show evidence of past infection
Mycobacterium tuberculosis Waxy apperance


Fig. Diagnosing diphtheria: gross pharyngitis, tonsilitis, grey patches (pseudomembrane) and swelling

Lyme Disease- tick transmitted Lyme disease (sometimes mistakenly referred to as lime disease) is a disease carried by deer ticks which was first identified and diagnosed in Lyme, Connecticut. It sometimes produces a well-known "bull's eye" rash around the tick bite - but not always. It can be effectively treated with antibiotics in the early stages. However, if left untreated Lyme disease may result in a myriad of symptoms ranging from light dizziness to joint pain and, in the later stages, nervous system disorders and chronic memory loss.
- Slides: 14